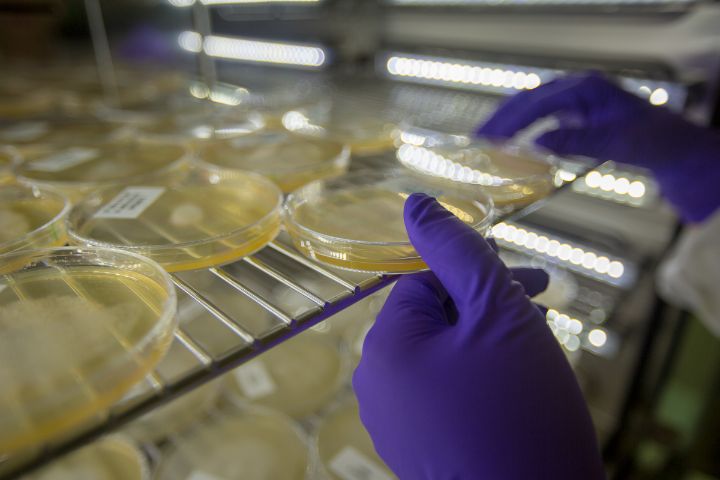
Gestes métiers - Copyright xanata.photo / Thierry Vallée

Marathon photo FNAC
1° prix Marathon photo FNAC - Copyright xanata.photo / Thierry Vallée

1° prix Marathon photo FNAC - Copyright xanata.photo / Thierry Vallée

Oakley surf shop challenge - Copyright xanata.photo / Thierry Vallée

Architecture - Copyright xanata.photo / Thierry Vallée
Gestes métiers - Copyright xanata.photo / Thierry Vallée

Analyse de végétaux sous U.V. - Copyright xanata.photo / Thierry Vallée

Gestes métiers - Copyright xanata.photo / Thierry Vallée

Bec d'Ambès - vue drone - Copyright xanata.photo / Thierry Vallée

Appartement Maison - Location ou Ventes - Copyright xanata.photo / Thierry Vallée

Gestes métiers - Copyright xanata.photo / Thierry Vallée

Architecture 'La Défense - Paris' - Copyright xanata.photo / Thierry Vallée

Bâtiments - vue drone - Copyright xanata.photo / Thierry Vallée

Gestes métiers - Copyright xanata.photo / Thierry Vallée

Pont Chaban-Delmas - Copyright xanata.photo / Thierry Vallée

circuit moto - vue drone - Copyright xanata.photo / Thierry Vallée

Gestes métiers - Copyright xanata.photo / Thierry Vallée